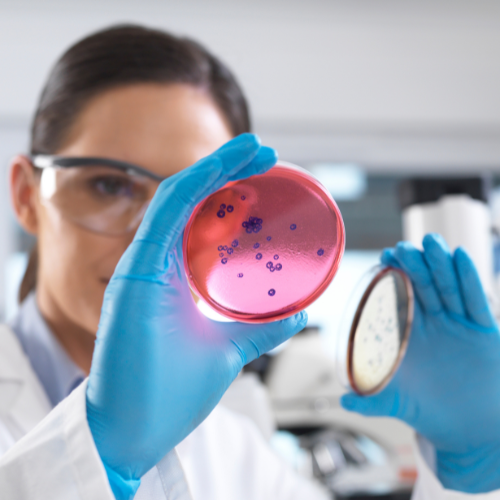

Laboratoire de Biologie Médicale DR MASSEN
Le Laboratoire d’Analyses Médicales Dr Dellala – Touchene à Saoula offre une gamme complète de tests biologiques pour le diagnostic et le suivi médical. Grâce à des équipements modernes et une équipe qualifiée, nous garantissons des résultats fiables et un accompagnement personnalisé pour votre santé.


A propos
Infrastructure Moderne
Accessibilité 7 Jours / 7, Jours Fériés Compris
Engagement Social et Confidentialité
Remise de résultats sur internet
Le Laboratoire de Biologie Médicale DR MASSEN à Alger Centre accompagne patients et médecins dans la démarche diagnostique grâce à des analyses fiables et rapides. Doté d’un plateau technique de dernière génération et d’une équipe médicale expérimentée, le laboratoire prend en charge tous types d’examens biologiques, avec ou sans rendez-vous, dans un cadre professionnel, humain et confidentiel.


Cerba et Biomnis
Dans le cadre de son engagement pour une prise en charge complète et de qualité, le Laboratoire de Biologie Médicale DR MASSEN collabore avec des laboratoires internationaux de référence, tels que Cerba et Biomnis en France. Cette coopération permet la sous-traitance d’analyses spécialisées ou rares, nécessitant des équipements de haute technologie et une expertise de pointe. Grâce à ce partenariat, nous assurons à nos patients des résultats fiables, traçables et rendus dans des délais maîtrisés, même pour les examens les plus complexes. Chaque échantillon fait l’objet d’un suivi rigoureux jusqu’au traitement final, garantissant un diagnostic précis et de confiance.
Prenez soin de votre santé avec des analyses fiables et rapides. Contactez le Laboratoire DR MASSEN dès aujourd’hui pour une prise en charge sans rendez-vous.
Appelez nous

F.A.Qs
Oui, le laboratoire accueille les patients avec ou sans rendez-vous pour la majorité des analyses courantes.
Les résultats sont généralement disponibles sous 24 à 48 heures selon le type d’analyse. Certains examens spécialisés peuvent nécessiter plus de temps.
Certaines analyses, comme le dosage de la glycémie ou du cholestérol, exigent d’être à jeun pendant 8 à 12 heures. Cela vous sera précisé au moment de la demande.
Oui, notre service de pharmaco-toxicologie propose des analyses de dépistage de substances médicamenteuses, toxiques ou illicites.

Ce que disent nos clients
Trustindex verifies that the original source of the review is Google. Trustindex verifies that the original source of the review is Google. Trustindex verifies that the original source of the review is Google. Trustindex verifies that the original source of the review is Google. Trustindex verifies that the original source of the review is Google. Google rating score: 4.0 of 5, based on 65 reviews
